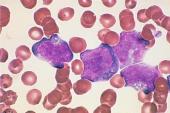
用“母细胞”造句

- (1)八体宏布,子母分施。天地定位,山泽通气,雷风相薄,水火不相射。(2)人告曾子母曰:“‘曾参杀人。’曾子之母曰:‘吾子不杀人。’织自若。”。(3)采子母式油压缸,上升速度快,提高产能.(4)本文
- (1) 结果:54例患者睾丸活检减数分裂分析阻滞在粗线期45例,单价体6例,多价体2例,正常减数分裂1例。(2) 当你作两个数的减法时,你用一个被减数去减另一个减数.(3) 对甘蓝型油菜与诸葛菜的杂
- 1 当你作两个数的减法时,你用一个被减数去减另一个减数.2 方法二:从被减数里减去算出的差,看是不是等于减数。3 方法一:用算出的差和减数相加,看是不是等于被减数。4 当最后借位为1时,将被减数重新
- 1. 采用体外诱导卵母细胞成熟技术,比较研究了雌核发育银鲫和两性融合发育彩鲫卵母细胞成熟过程中周期蛋白合成和MPF活性变化情况。2. 结果表明海狸鼠卵母细胞与其它啮齿动物的卵母细胞一样,能够在体外培